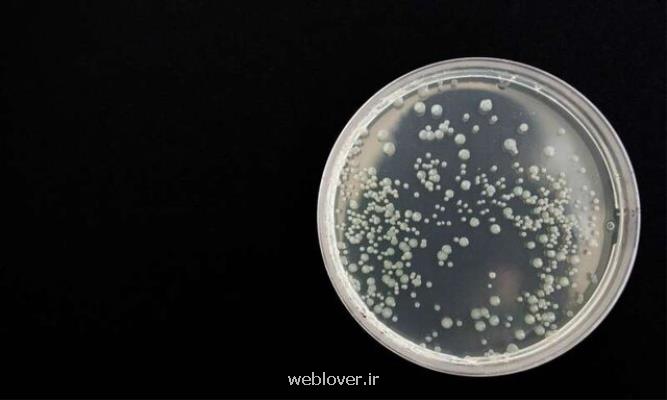

به گزارش عاشق وب دانشمندان ˮدانشگاه شفیلدˮ انگلیس می گویند: قرار گرفتن برنج در...
استاندارد
دانشمندان ˮدانشگاه کمبریجˮ در مطالعه اخیرشان از توالی ژنوم برای آشکار کردن میزان گسترش...
خراسان رضوی در ابتداء شیوع بیماری همه گیر کووید-۱۹، خیلی از تولیدکنندگان سراسر جهان...
به گزارش عاشق وب فضانوردان مأموریت اکسپدیشین ۶۳ بعد از ۶ ماه حضور در...
عاشق وب: مشاوره جهت خرید محصولات و پشتیبانی در بادیمن به صورت کاملا رایگان...
به گزارش عاشق وب معاون طراحی و تضمین مأموریت پژوهشگاه فضایی ایران با اشاره...
لوگوی شما همچنین میتواند فرصتی برای بیان یک بیانیه در مورد سازمان شما باشد،...
به گزارش عاشق وب به قول رئیس سازمان تنظیم مقررات و ارتباطات رادیویی، قابلیت...
عاشق وب: سؤال اینجا است که چه مزیت هایی سبب شده تا قریب به...
به گزارش عاشق وب از جانب صندوق نوآوری و شکوفایی رویداد مجازی معرفی نیازهای...